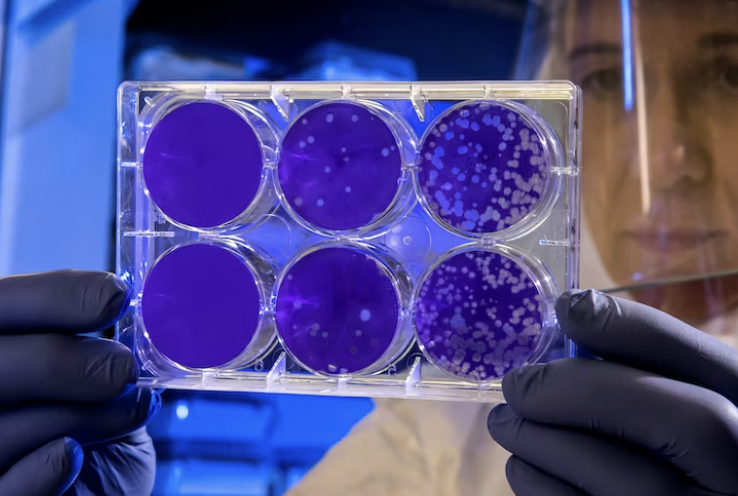
세스코 가정집 비용

세스코 가정집 비용 및 무료진단 서비스에 대해 알려드리겠습니다. 해충이나 벌레 박멸로 유명한 세스코 업체는 규모가 큰 건물 외에 가정집에서도 생각보다 저렴한 비용으로 세스코 업체 솔루션을 받을 수 있습니다. 특히나 바퀴벌레는 1~2마리가 등장했다는 것은 최소 몇 백마리가 근처에 있다는 것이기 때문에 완전한 박멸이 아니고서야 금세 나타나기 마련입니다. 따라서 완전한 박멸을 위해 업체를 부르는 것이 효과적이랍니다.
심지어 세스코에서는 요즘 기승을 부리는 빈대 진단도 무료로 진행해 주기 때문에 이번 기회에 무료진단을 신청해 보시는 것을 추천드립니다.
세스코 가정집 비용 무료진단 방법
세스코 무료진단을 신청하면 세스코 업체의 전문 직원이 해당 가정을 방문하여 진단을 진행합니다. 잘 모르는 채로 신청하게 될 경우 의미 없는 해충 처리를 진행할 수 있는데요. 세스코에서 직접 방문해 어떤 것이 문제인지 정확히 진단해 주니까 더 명확하게 처리할 수 있어서 믿고 맡길 수 있습니다.
전체적으로 진단 후에 원인 및 솔루션과 함께 진드기 케어와 세스코 시험 분석 등을 무료로 진행해 줍니다.
세스코 가정집 비용
세스코와 같은 업체를 사용하면 비용이 굉장히 비쌀 것 같은 느낌이 듭니다. 하지만 예상만큼 비싸지 않아서 고려해 보아도 좋을 것 같습니다.
| 정기방역 | 초기방역 | 홈멤버스 가격 | |
| 원룸 (10평 이하) |
2만원 ~ 2만 5천원 | 16 ~ 17만원 | 3만원 |
| 투룸 및 일반 가정집 (30평 이하) |
2만 5천원 ~ 3만원 | 19 ~ 20만원 | 3만 5천원 ~ 4만원 |
| 30평 대 | 22 ~ 23만원 | 4만원 ~ 5만원 | |
| 40평 대 | 3만원 ~ 3만 5천원 | 25 ~ 26만원 | 4만 5천원 ~ 5만원 |
물론 세스코 가정집 비용은 평수와 어떤 해충인지, 주기가 얼마나 되는지 정도에 따라서 비용이 달라질 수 있어서 정확한 비용은 세스코 진단 후에 확인할 수 있습니다. 보통 일반 가정집은 투룸부터 ~ 40평대 이하 범위 내에서 진행할 수 있을 것으로 예상됩니다.
* 정기 방역은 10개월 텀으로 진행하는 것이고 초기 방역은 최초 1회성이며 홈멤버스는 1년 단위의 멤버십입니다.



세스코 솔루션 종류
세스코 솔루션은 해충 박멸만 있는 것이 아니라 다양한 종류가 있습니다.
- 통합 해충 방제 : 세스코 전문가가 방문 후 진단 및 상담
- 바이러스케어 공기 살균기 : 공간 내의 바이러스들을 없애고 쾌적하게 살균을 진행합니다.
- 수질 안심 관리 : 정수기를 통해 마시는 물의 수질을 관리받을 수 있습니다.
- 공기질 안심 관리 : 공간 내에 공기를 쾌적하게 하기 위한 관리
- 향기 컨설팅 : 자신이 운영하는 사업장이나 기타 공간들에 적합한 향기 컨설팅을 받을 수 있습니다.
- 바디케어 유어핏 비데 : 매일 앉게 되는 비데를 세스코 살균 과학이 담긴 제품으로 사용할 수 있습니다.
- 식품안전 : 식자재 및 식품 위생관리를 위한 솔루션입니다.
- 시험분석 : 국제적인 공신력을 갖춘 전문적인 분석 서비스입니다.
- 진드기 케어 솔루션 : 해충 전문가의 진드기 박멸을 진행할 수 있습니다.
세스코 가정집 비용 셀프진단
세스코 진단을 부르기 전에 미리 셀프 진단을 할 수 있는데요. 쥐, 바퀴벌레, 개미 등 의심되는 상황이 있으시다면 셀프진단으로 먼저 확인해 보시기 바랍니다.
함께 보면 좋은 내용